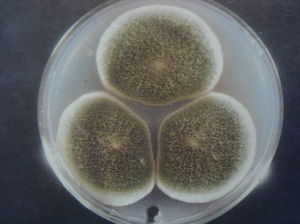
麴黴菌的培養皿

概述
 麴黴菌
麴黴菌麴黴菌常導致角膜炎和眼內炎,偶見引起鞏膜炎、結膜炎及淚囊炎。
另有米麴黴、醬油麴黴是常用發酵菌種。黃麴黴的有些菌系能產生黃麴黴毒素,不僅能引起禽畜中毒致死,亦有致癌作用。
生物學形態特徵
營養菌絲具有分隔;氣生菌絲的一部分形成長而粗糙的分生孢子梗,頂端產生燒瓶形或近球形頂囊,表面產生許多小梗(一般為雙層),小梗上著生成串的表面粗糙的球形分生孢子。分生孢子梗、頂囊、小梗和分生孢子合成孢子頭,可用於產生澱粉酶、蛋白酶和磷酸二酯酶等,也是釀造工業中的常見菌種。
麴黴菌占空氣中真菌的12%左右,主要以枯死的植物、動物的排瀉物及動物屍體為營養源,為寄生於土壤中的腐生菌。其形態特徵是在分生孢子的頭部有一個頂囊。已知的麴黴菌至少有170種以上,各個菌種形成的菌落,顏色不一樣,可用以菌種的鑑別。最適生長溫度為25-30℃。
感染臨床表現及檢查
麴黴菌性角膜炎
麴黴菌菌落形態
麴黴菌菌落形態裂隙燈檢查:
1、病灶呈硬性感、雲霧狀;
2、邊緣呈毛刷狀;
3、可見菌絲從潰瘍中心伸向邊緣實質;
4、衛星病灶;
5、病灶小,但炎症反應重----前房積膿、後彈力膜皺襞、內皮斑、免疫環。
麴黴菌性眼內炎
病史:
1、患者免疫功能低下:白血病、器官移植術後、抗癌藥物治療等,或患者施行靜脈內高營養輸液;
2、存在外眼麴黴菌感染;
3、藥物中毒史或穿孔性眼外傷、眼內手術史
眼底檢查:
1、後極部可見小圓形白色或黃白色滲出斑,向玻璃體隆起;
2、玻璃體中可見羽毛狀或串珠狀混濁;
實驗室檢查:
直接鏡檢和分離培養是確診的唯一辦法。用做鏡檢的標本可做革蘭氏、PAS、KOHParkerInk染色。分離培養一般選擇薩布羅培養基。對於角膜真菌感染應採取病變邊緣部位的標本,分離率高。眼內炎則應取玻璃體液,過濾後鏡檢或培養,分離率高。
感染後治療原則
氟康唑:對於麴黴菌效力較差,但具有副作用少、眼內移行性好及半衰期長等優點。同咪康唑混合注射,效果相加。該藥可用做靜脈滴注、結膜下注射、口服及點眼。
咪康唑:抗麴黴菌的效力大於福康唑,但有肝功能障害及消化器症狀等副作用。可用靜脈滴注液稀釋10倍後點眼。
匹馬黴素:對於角膜真菌感染效果較好。局部用藥的副作用包括上皮生長障害、結膜充血及眼瞼炎等。
氟胞嘧啶:作用強,副作用大。採用口服。
兩性黴素B:作用強,副作用多,可靜脈滴注、口服或點眼。對於眼內炎可採取玻璃體腔注藥療法。一般咪康唑25-50微克、二性黴素5-10微克/1次。
由於各種真菌對於藥物的敏感性有一定的差異,有條件時應做藥物敏感試驗。根據試驗結果選擇抗真菌類藥物。一般麴黴菌感染比鐮刀菌感染所致者預後要好。藥物治療效果不佳者,可選擇做角膜移植或玻璃體切割手術。

